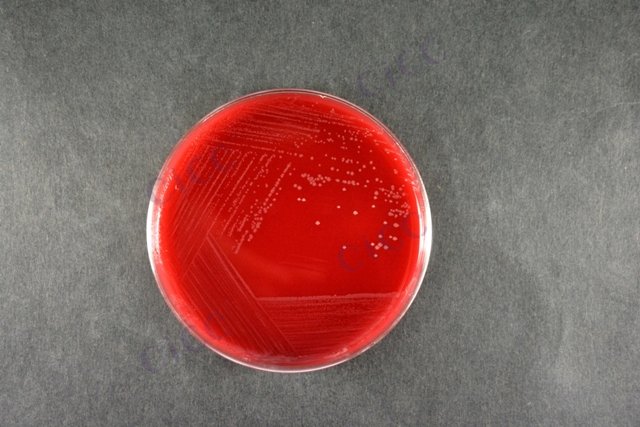
Campylobacter jejuni subsp jejuni

Campylobacter jejuni subsp jejuni
-
Campylobacter jejuni subsp jejuni
CICC 25392 | 见证书
-
Campylobacter jejuni subsp jejuni
CICC 25358 | 见证书
-
空肠弯曲杆菌 Campylobacter jejuni subsp. jejuni ATCC 29428 Culti-Loop Campylobacter jejuni subsp. jejuni ATCC 29428
R4601410 | 5支/包
-
Campylobacter jejuni subsp. jejuni derived from NCTC 13367
0712K | 6支/盒
-
Campylobacter jejuni subsp. jejuni derived from NCTC 13367
0712L | 6颗/瓶
-
Campylobacter jejuni subsp. jejuni derived from NCTC 13367
0712P | 2支/盒
-
Campylobacter jejuni subsp. jejuni derived from NCTC 11322
0718L | 6颗/瓶

说明书下载: 菌种说明书 打管说明书
您正在浏览的产品:空肠弯曲菌空肠亚种 Campylobacter jejuni subsp jejuni CICC 24752
手机版:空肠弯曲菌空肠亚种 Campylobacter jejuni subsp jejuni CICC 24752
本公司销售的所有产品仅供实验科研使用,不用于人体及临床诊断。